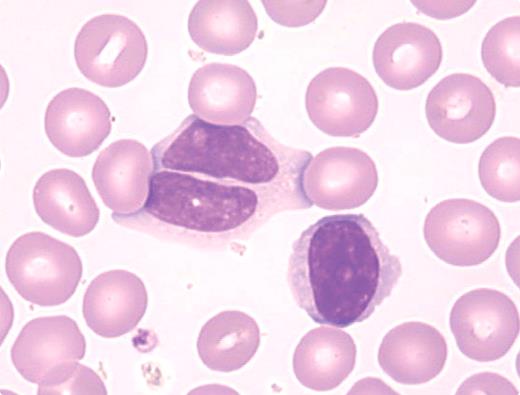
A 45-year-old woman had asthenia, diffuse myalgias, and mild splenomegaly. Her history included smoking and no evidence of viral illness. There was no family history of lymphoid disorders. Laboratory tests showed lymphocytosis (6.1 × 109/L) that had been present for years without anemia and thrombocytopenia. Peripheral blood smears usually show ∼ 10% of the lymphocytes as binucleated (see figure). A polyclonal increase of serum IgM (10.1 g/L) has been present. Immunophenotyping demonstrated a polyclonal population of B lymphocytes (IgM+, IgD+, CD19, CD20, CD27, and FMC7 positivity and CD5, CD10, CD23, and CD43 negativity). Karyotype and FISH revealed an isochromosome for the long arm of chromosome 3, +i(3q), and an acquisition of +3 and +18. Tests for viral infection, hormone abnormalities, and connective tissue diseases have been negative. A diagnosis of persistent polyclonal B-cell lymphocytosis (PPBL) was made and her case has remained stable for 12 years. Although lymphocytosis has increased (11.9 × 109/L), there has been no evidence of malignant lymphoma transformation. / PPBL is an infrequent disorder, characterized by chronic lymphocytosis, binucleated lymphocytes, polyclonal increases in IgM, and cytogenetic abnormalities of chromosome 3. Many of the patients are middle-aged women who smoke. This polyclonal disorder rarely converts to malignant lymphoma.

A 45-year-old woman had asthenia, diffuse myalgias, and mild splenomegaly. Her history included smoking and no evidence of viral illness. There was no family history of lymphoid disorders. Laboratory tests showed lymphocytosis (6.1 × 109/L) that had been present for years without anemia and thrombocytopenia. Peripheral blood smears usually show ∼ 10% of the lymphocytes as binucleated (see figure). A polyclonal increase of serum IgM (10.1 g/L) has been present. Immunophenotyping demonstrated a polyclonal population of B lymphocytes (IgM+, IgD+, CD19, CD20, CD27, and FMC7 positivity and CD5, CD10, CD23, and CD43 negativity). Karyotype and FISH revealed an isochromosome for the long arm of chromosome 3, +i(3q), and an acquisition of +3 and +18. Tests for viral infection, hormone abnormalities, and connective tissue diseases have been negative. A diagnosis of persistent polyclonal B-cell lymphocytosis (PPBL) was made and her case has remained stable for 12 years. Although lymphocytosis has increased (11.9 × 109/L), there has been no evidence of malignant lymphoma transformation.
PPBL is an infrequent disorder, characterized by chronic lymphocytosis, binucleated lymphocytes, polyclonal increases in IgM, and cytogenetic abnormalities of chromosome 3. Many of the patients are middle-aged women who smoke. This polyclonal disorder rarely converts to malignant lymphoma.
A 45-year-old woman had asthenia, diffuse myalgias, and mild splenomegaly. Her history included smoking and no evidence of viral illness. There was no family history of lymphoid disorders. Laboratory tests showed lymphocytosis (6.1 × 109/L) that had been present for years without anemia and thrombocytopenia. Peripheral blood smears usually show ∼ 10% of the lymphocytes as binucleated (see figure). A polyclonal increase of serum IgM (10.1 g/L) has been present. Immunophenotyping demonstrated a polyclonal population of B lymphocytes (IgM+, IgD+, CD19, CD20, CD27, and FMC7 positivity and CD5, CD10, CD23, and CD43 negativity). Karyotype and FISH revealed an isochromosome for the long arm of chromosome 3, +i(3q), and an acquisition of +3 and +18. Tests for viral infection, hormone abnormalities, and connective tissue diseases have been negative. A diagnosis of persistent polyclonal B-cell lymphocytosis (PPBL) was made and her case has remained stable for 12 years. Although lymphocytosis has increased (11.9 × 109/L), there has been no evidence of malignant lymphoma transformation.
PPBL is an infrequent disorder, characterized by chronic lymphocytosis, binucleated lymphocytes, polyclonal increases in IgM, and cytogenetic abnormalities of chromosome 3. Many of the patients are middle-aged women who smoke. This polyclonal disorder rarely converts to malignant lymphoma.
Many Blood Work images are provided by the ASH IMAGE BANK, a reference and teaching tool that is continually updated with new atlas images and images of case studies. For more information or to contribute to the Image Bank, visit http://imagebank.hematology.org.